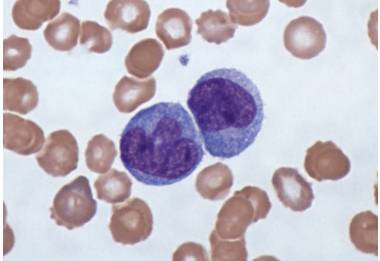

Содержание
Моноциты образуются в костном мозге и являются одним из самых главных компонентов крови, который борется с вирусами, онкологическими заболеваниями и другими патологиями. Благодаря ним, улучшается работа иммунной системы. Повышение уровня этого компонента в крови необходимо лечить, потому что это говорит о нарушениях в организме. Часто причиной моноцитоза становится сахарный диабет, волчанка, лейкемия, проблемы с гормональным фоном, сифилис и другие болезни.
Для женщины, вынашивающей ребёнка, характерно понижение в крови этого компонента. После родов он приходит в норму в течение месяца. Но возникают ситуации, когда уровень моноцитов растёт. Обычно это состояние развивается при иммунодефицитных состояниях, потому как они берут на себя роль лимфоцитов и осуществляют защиту от вредоносных агентов.
Моноциты стараются уберечь женщину от вирусных и инфекционных заболеваний, выделяя большое количество цитокинов.
Если норма меняется незначительно, то значит, организм смог справиться с инфекционной нагрузкой самостоятельно.
Если повышение длительное, то врачам предстоит понять причину этого состояния и назначить лечение.
Моноцитоз – это не конкретная болезнь, а следствие проникновения в женский организм паразитов, вирусов, инфекций и повышение уровня моноцитов для защиты от них.
Каким анализом определяют?
Выявить, что моноциты повышены при беременности, можно с помощью общего анализа крови. Измерения моноцитов происходит по двум шкалам: абсолютной и в процентном соотношении к другим клеткам лейкоцитной группы.
Если у пациентки диагностировано серьёзное заболевание, то необходим осмотр, дополнительные анализы каловых масс и мочи.
Врачи рекомендуют дополнительно проводить УЗИ внутренних органов, МРТ, исследуют мокроту и мазок из влагалища.
Основным анализом является общий анализ крови, но пациентке необходимо соблюдать ряд правил, чтобы непреднамеренно не исказить результаты исследования.
Посмотрите видео на эту тему

Повышенные моноциты во время беременности могут вызывать беспокойство у будущих мам. Врачи отмечают, что это состояние может быть связано с различными факторами, включая инфекции, воспалительные процессы или даже стресс. Важно не паниковать, а обратиться к специалисту для дальнейшего обследования. Обычно врачи рекомендуют провести дополнительные анализы, чтобы выяснить причину повышения уровня моноцитов. В зависимости от результатов, может потребоваться лечение или наблюдение. Также важно следить за общим состоянием здоровья, правильно питаться и избегать стрессовых ситуаций. Регулярные консультации с врачом помогут контролировать ситуацию и обеспечить безопасность как для матери, так и для ребенка.

Правила сдачи анализа

Человек не должен есть за 8 часов до забора крови, но можно пить воду или минералку без газа. Количество потребляемой жидкости не должно быть большим.
Анализ обязательно сдаётся утром. Накануне и в день забора крови беременной женщине рекомендуется не нервничать, не заниматься спортом, нельзя давать телу физические нагрузки.
Обычно анализ проводят в ситуациях, когда у пациентки подозревается развитие анемии, лейкоз, туберкулёз, заражения крови, малярии и других заболеваний.
Что может повлиять на искажение результатов исследований?
Негативно влияет на достоверность проводимого анализа время суток, курение, наркотические средства и алкогольные напитки, которые употребил пациент.
Кроме того, похожим действием обладают некоторые лекарственные медикаменты.
Если пациент ел, нервничал, интенсивно нагружал своё тело тренировками, то анализ на моноциты может быть тоже недостоверным.
Немаловажное значение имеют действия лаборанта. Тут влияет, правильно ли, осуществлён забор крови, в какую посуду, какие консерванты используют в результате исследования.
Негативно также влияет время забора крови, воздействие света и время, которое транспортировался биологический материал на место непосредственного исследования.
У этой группы женщин обязательно следует учитывать срок беременности, потому что организм наращивает объем крови, мочи, изменяются другие показатели.
Повышенные моноциты во время беременности могут вызывать беспокойство у будущих мам. Многие женщины делятся своими переживаниями на форумах и в социальных сетях, обсуждая, что это может означать для их здоровья и здоровья малыша. Некоторые отмечают, что врачи объясняют, что не всегда повышение моноцитов является признаком серьезной проблемы. Это может быть реакцией организма на инфекции или воспалительные процессы. Важно, чтобы беременные женщины регулярно проходили обследования и следовали рекомендациям врачей. Многие советуют не паниковать, а сосредоточиться на здоровом образе жизни, правильном питании и достаточном отдыхе. Общение с другими мамами и получение информации от специалистов помогает снизить уровень тревожности и лучше понять, как действовать в данной ситуации.

Какой уровень считать повышенным для беременных?
Повышение уровня этого компонента может вызывать снижение иммунитета, но при этом моноциты выделяют противовоспалительные вещества в кровь.
Во время беременности у женщин меняется процентное соотношение клеток крови из-за изменения в иммунной и эндокринной системе.
Что это значит? Организм настраивается на рост малыша и обеспечение его правильного развития.
На первых месяцах беременности моноциты снижаются, и их нормой считается граница от 1 до 11%.
Это считается нормальным состоянием, и восстановление моноцитов происходит уже после родов. Их увеличение происходит в течение 3 недель после родового процесса.
Уровень моноцитов в крови у женщин может повышаться из-за возникновения инфекций, проблем с желудочно-кишечным трактом, грибка, вирусов, лейкозов.
| Группа пациенток | Средние показатели компонента, % |
| Небеременные | 3–11 |
| Первый триместр | 3–6 |
| Второй триместр | 4–6 |
| Третий триместр | 4–5 |
Повышенным уровнем моноцитов на первом триместре беременности считается показатель выше 6%, на втором триместре выше 6%, на третьем триместре выше 5%.
Повышенные моноциты в крови могут свидетельствовать о серьёзных аутоиммунных нарушениях, проблемах с кроветворением, онкологии.
В некоторых случаях повышение моноцитов обусловлено наследственностью, проблемами с гормональным фоном, стрессовыми ситуациями, инфекциями, например, ротавирусной инфекции.
Симптомы и признаки моноцитоза
Клиническая картина моноцитоза

Если повышение незначительное, то организм в состоянии справится с болезнью самостоятельно при серьёзных отклонениях необходимо лечение у врача.
Кроме того, беременную женщину может беспокоить ломота в теле, боли в суставах.
Зачастую пациентки не обращают внимания на такие симптомы, считая их началом лёгкой простуды, и обращаются к врачу, когда симптомы заболевания не проходят, и становится сильнее.
Опасности и последствия для мамы и будущего ребёнка
Чем может грозить это заболевание беременной женщине и плоду?
Всё зависит от заболевания, которое вызвало это состояние. Тем тяжелее оно протекает и опасней для организма, тем тяжелее последствия.
Моноцитоз, если его не лечить, может закончиться инвалидностью и даже смертью.
В лучшем случае, вынашивание ребёнка закончится инфицированием будущего малыша, выкидышем или необходимостью аборта.
Повышение этого компонента в крови осложняет роды, увеличивает риск приобретения внутриутробных патологий.
У женщины могут отказать отдельные органы, а ребёнок после рождения может отставать в развитии, как умственном, так и физическом.
Что делать?
Женщинам ни в коем случае нельзя заниматься самолечением, чтобы не усугубить своё состояние. Это состояние требует тщательной диагностики для выявления причин, которые спровоцировали подобное состояние.
Какое лечение назначают?
В качестве лечения используется медикаментозная терапия антибактериальными препаратами. Это поможет ликвидировать вредные бактерии и снизить вероятность возникновения серьёзных патологий плода.
В некоторых случаях может применяться стационарное лечение с переливанием крови и плазмаферезом, операцией.
Пациентку обязательно садят на диету, ей рекомендуется проводить физиотерапевтические процедуры.
Необходимо симптоматическое лечение и курс витаминов.
Профилактика
- Чтобы у женщины не начинался моноцитоз необходимо постоянно поддерживать работу её иммунной системы.
- Для этого следует больше гулять на свежем воздухе. При этом рацион должен быть сбалансированным.
- Беременной пациентке необходимо двигаться, чтобы у неё была физическая нагрузка.
- Помещения, в котором находится женщина, чаще проветривают. Следует избегать вирусных заражений во время инфекции. Для этого следует промывать нос солевым раствором.
- Если моноциты в крови повышены, то необходимо время от времени проветривать и увлажнять воздух в помещении и время от времени проходить анализы, чтобы успеть захватить развивающиеся заболевания на ранней стадии.
Вывод

Поэтому женщине, вынашивающей ребёнка, очень важно время от времени проходить диагностику и соответствующие анализы. При выявлении нарушений и резком повышении уровня компонента в крови врачи рекомендуют пройти лечение медикаментами.
Немаловажно в этот период правильно питаться.
В исключительных ситуациях делают хирургическое вмешательство.
Чтобы моноцитоз не начался, женщине следует больше двигаться, питаться сбалансировано, избегать инфекций, давать организму физическую нагрузку.
Вопрос-ответ
Почему повышены моноциты у беременных?
Незначительное повышение числа моноцитов при беременности, особенно в первом триместре, не считается патологией. В этом случае иммунитет адаптируется под состояние беременности и усиливает защитные функции.
Нормальны ли высокие моноциты во время беременности?
Здоровая беременность характеризуется провоспалительным состоянием, которое проявляется увеличением количества моноцитов и их активацией, а также увеличением количества промежуточных моноцитов и снижением количества классических моноцитов. Это может свидетельствовать о созревании моноцитов.
Что делать, если повышены моноциты?
Обязательно обратиться к доктору. Возможно, он назначит вам, кроме общего анализа крови, дополнительные исследования. Например, МРТ легких, УЗИ органов в брюшной полости, КТ суставов. Дальнейшее лечение напрямую зависит от установленного диагноза.
Советы
СОВЕТ №1
Обязательно проконсультируйтесь с врачом. Повышенные моноциты могут указывать на различные состояния, поэтому важно получить профессиональную оценку и рекомендации от специалиста, который сможет назначить необходимые анализы и лечение.
СОВЕТ №2
Следите за своим питанием. Убедитесь, что ваш рацион богат витаминами и минералами, особенно витаминами группы B, C и D, а также железом. Это поможет поддерживать иммунную систему и общее состояние здоровья во время беременности.
СОВЕТ №3
Регулярно проходите медицинские обследования. Посещение врача и выполнение всех назначенных анализов поможет контролировать уровень моноцитов и выявить возможные проблемы на ранней стадии.
СОВЕТ №4
Обратите внимание на уровень стресса. Стресс может негативно влиять на иммунную систему, поэтому старайтесь находить время для отдыха и релаксации, занимайтесь йогой или медитацией, чтобы поддерживать эмоциональное равновесие.


